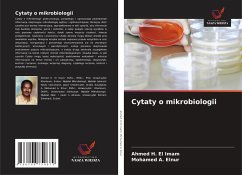

Suchergebnisse für "Wydawnictwo Nasza Wiedza"
5000 Artikel gefunden
Zur ersten SeiteZur vorherigen Seite...Weitere Seiten 40 Zur Seite 40 41 Zur Seite 41 42 Zur Seite 42 43 Aktuelle Seite 44 Zur Seite 44 45 Zur Seite 45...Weitere Seiten99+Zur letzten Seite, Seite 100Zur nächsten SeiteZur letzten Seite
Zur ersten SeiteZur vorherigen Seite...Weitere Seiten 42 Zur Seite 42 43 Aktuelle Seite...Weitere Seiten99+Zur letzten Seite, Seite 100Zur nächsten SeiteZur letzten Seite
Ähnlichkeitssuche: Fact®Finder von OMIKRON